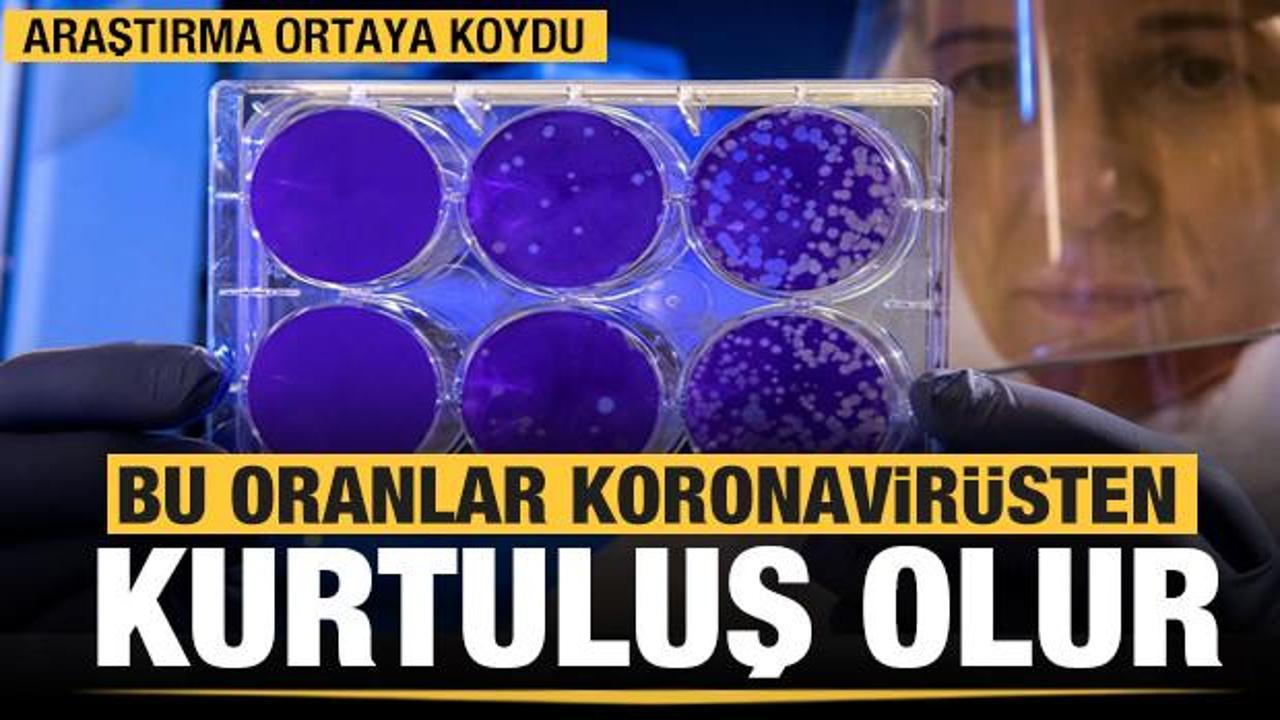
Dünyayı Saran Tehlike Koronavirüs (Kovid-19)

Dünyayı Saran Tehlike Koronavirüs (Kovid-19)
Geçtiğimiz hafta ülkemizde de ilk vakanın tespit edildiği Kovid-19 tipi koronavirüs ile ilgili NG Araştırma şirketi olarak bir kamuoyu araştırması yaptı. Yapılan araştırma şu ana kadar Türkiye genelinde ve en fazla kişiyle yapılan çalışma olması açısından ayrı bir önem taşımaktadır

Koronavirüs hayatımızın bir parçası haline gelirken bu konu hakkında ne kadar bilgi sahibiyiz ve ne gibi önlemler alınıyor? sorularının cevapları araştırmalarda yanıt buldu.
KORONAVİRÜS HAKKINDA NE KADAR BİLGİLİYİZ?
Çok hızlı bulaştığı için kısa süre içinde tüm dünya ülkelerinde görülmeye başlandı. 16 Mart 2020 itibariyle dünya genelinde hayatını kaybeden kişi sayısı 6 bin 606’ya, teyit edilmiş hasta sayısı ise 167 bin 511’e yükselirken; bu sayılar her geçen gün artmaya devam ediyor.
PEKİ ÜLKE OLARAK KORONAVİRÜS HAKKINDA BİLGİ DÜZEYİMİZ NASIL?
Katılımcıların %64’ü koronavirüs hakkında yeterli bilgiye sahip olduklarını belirtirken, %35’i ise az da olsa bilgisi olduğunu belirtti. Koronavirüs hakkında hiç bilgisi olmayanların oranı ise %1’den daha az.
KORONAVİRÜSLE İLGİLİ BİLGİLERİ NEREDEN ÖĞRENDİK?
Koronavirüs oldukça hızlı yayılabiliyor. Bu nedenle hastalığın kontrol altına alınabilmesi ve hayati risklerin engellenebilmesi için herkesin bu hastalık hakkında bilgili olması önemli.
Katılımcılara koronavirüs ile ilgili bilgiyi hangi kaynaklardan edindiklerini sorduğumuzda medya kanallarının bir kez daha ne kadar önemli etkisi olduğunu görüyoruz.
Koranavirüsle ilgili televizyondan bilgi edinenlerin oranı %63, sosyal medya kanallarından öğrenenlerin oranı ise %60 oldu. Uzman doktor yorumlarını takip edenlerin oranı %42 olurken, kendi başına araştırma yapanların oranı ise %41. Çevresindekilerden bilgi alanların oranı ise %30.
KORONAVİRÜS BELİRTİLERİNİ BİLİYOR MUYUZ?
Uzmanlar Kovid-19’un sebep olduğu hastalığın belli belirtileri olduğu üzerinde hemfikirler. Sağlık Bakanlığı’nın verdiği bilgilere göre ateş, nefes almakta zorluk ve öksürük gibi belirtiler varsa en yakın sağlık kuruluşuna başvurulması gerekiyor. Peki bu belirtileri tam olarak ve başka hastalıkların belirtileriyle karıştırmadan biliyor muyuz?
Katılımcıların %96’sı koronavirüsün belirtilerini bildiğini söyledi. Fakat Sağlık Bakanlığı tarafından paylaşılan belirtileri tam ve doğru bir şekilde tanımlayabilenlerin oranı yalnızca her 3 kişiden 1’i. Bu kişilerin haricinde yaklaşık olarak her 3 kişiden 1’i de hastalığın tüm belirtilerinin yanı sıra başka hastalık belirtilerini de ekledi. Geri kalanlar ise hastalık belirtilerini ya tam olarak bilmiyor ya da başka hastalık belirtileriyle karıştırıyor. Bu sonuç gösteriyor ki bazı kişilerde bilgi kirliliği oluşmuş.
KORONAVİRÜS BELİRTİLERİNİN GÖRÜLME ORANI NE?
Sağlık Bakanlığı’nın yaptığı açıklamalara göre ülkemizde koronavirüse yakalanan hasta sayısında artış var. Kovid-19 tipi bu koronovirüsün kuluçka dönemi 14 gün. Uzmanların bahsettiği koronavirüs belirtilerinden herhangi birini son 1 ayda yaşadık mı?
Katılımcıların %79’u koronavirüs belirtilerinden herhangi birini geçirmediğini belirtti. %16’sı öksürük, %4’ü nefes darlığı ve % 4’ü ateş yaşadığını belirtti. Bu üç belirtiyi de yaşadığını belirtenlerin oranı ise %1. Fakat unutmayalım ki bu belirtiler soğuk algınlığı ve grip ile benzerlik göstermektedir. Doğru tanı için uzman sağlık personelinin teşhis koyması gerekmektedir.
VİRÜSTEN KORUNMAK İÇİN HANGİ ÖNLEMLERİ ALIYORUZ?
Koronavirüsten korunmak için dünya genelinde ve ülkemizde önlemler arttırılmaya devam ediyor. Sağlık Bakanlığı’nın aldığı önlemlerin yanında şirketler de çalışanları için önlemler almaya başladı. Peki, bizler kendimiz için önlem alıyor muyuz?
Her 10 kişiden 1’i koronavirüsten korunmak için herhangi bir önlem almadığını belirtti. Oran azınlıkta gibi görünse de çok hızlı bulaşabilen ve hayati riskler taşıyabilen böyle bir hastalık için azımsanmayacak kadar yüksektir.
Önlem alanların uyguladıkları yöntemlerin oranları şu şekilde sıralandı:
Bu cevapların yanı sıra kolonya ve sirke kullandığını belirtenler de görülüyor.
Kendi sağlığımızın yanı sıra sevdiklerimizin ve toplumun genel sağlığını etkileyecek bu konuda, uzmanların yaptığı açıklamaların yakından takip edilmesini bir kere daha hatırlatıyoruz. Sağlık Bakanlığı tarafından paylaşılan aşağıdaki videoyu izleyerek koronavirüs hakkında alınması gereken tedbirleri öğrenebilirsiniz.
-
Kayı Boyu 6 yıl önce Şikayet EtCANIM TÜRKİYEM: Bir tarafta 60 yaş üstü nüfusunu gözden çıkaran İngiltere, Hollanda, İtalya ve Avrupa diğer Tarafta o ülkelere bile yardım yapabileceğini teklif eden Türkiye.. Bir tarafta sigortan yok ise öl diyen ileri batı ülkeleri diğer tarafta 65 yaş üstü kişilerin evlerine bedava kolonya ve koruyucu maske dağıtan canım Türkiyem. Seninle gurur duyuyorum sevgili ülkem. Seninle gurur duyuyorum sevgili Cumhurbaşkanım.Beğen Toplam 6 beğeni
-
Testere 6 yıl önce Şikayet EtBıreysel yasamak bu surecte kaderımız allahın kullarına bır cezasıda bu eee ınsanlar azdı buda rabbımın ofkesı kımsenın hala aklı basına gelmıs degıl!Beğen Toplam 2 beğeni
-
cnk 6 yıl önce Şikayet Etarkadaşlar devletimizin bir an evvel tüm ülke genelinde tüm insanları teste tabi tutarsa büyük ölçüde önüne geçmiş olur, her ilde kriz masaları oluşturularak tespit edilenler hemen tedaviye alınır geri kalanlara da aydınlatıcı bilgiler verilir virüse yakalanmamak için Devletimiz güçlüdür evvel Allahın izniyle bununda üstesinden gelir Allahın izniyleBeğen Toplam 3 beğeni
-
master 6 yıl önce Şikayet Etişaret parmagını burnundan sokarak beynini karıştıran abiler amcalar burnu akınca avuç içiyle slap slap silen sonrada otobüsteki tutamakları tutan yine abiler amcalar, öksürürken ve hapsururken koyveren gittiği yere kadar gitsin diyen yine abiler amcalar lütfen yeter artık biraz Tv dinleyin Bakanlık ne diyor doktorlar ne diyor nasıl davranacaz öğrenin artık, umursamaz davranışlarınız birçok insanı tedirgin ediyor etrafınıza bakmıyormusunuz size tiksinerek bakan insanları görmüyormusunuz. haya edin insan evinde bile yapmayacagı şeyleri heryerde yapıyorsunuz.(yapmayanlara sözüm yok)Beğen Toplam 8 beğeni
-
mefa 6 yıl önce Şikayet EtMillet tatil yerlerine gitmiş. Oralarda hiç tedbir yok. Herkes bildiğini okuyor. Devlet tedbir alıyor. İnsanımız milletin sağlığını riske atıyor.Beğen Toplam 6 beğeni


